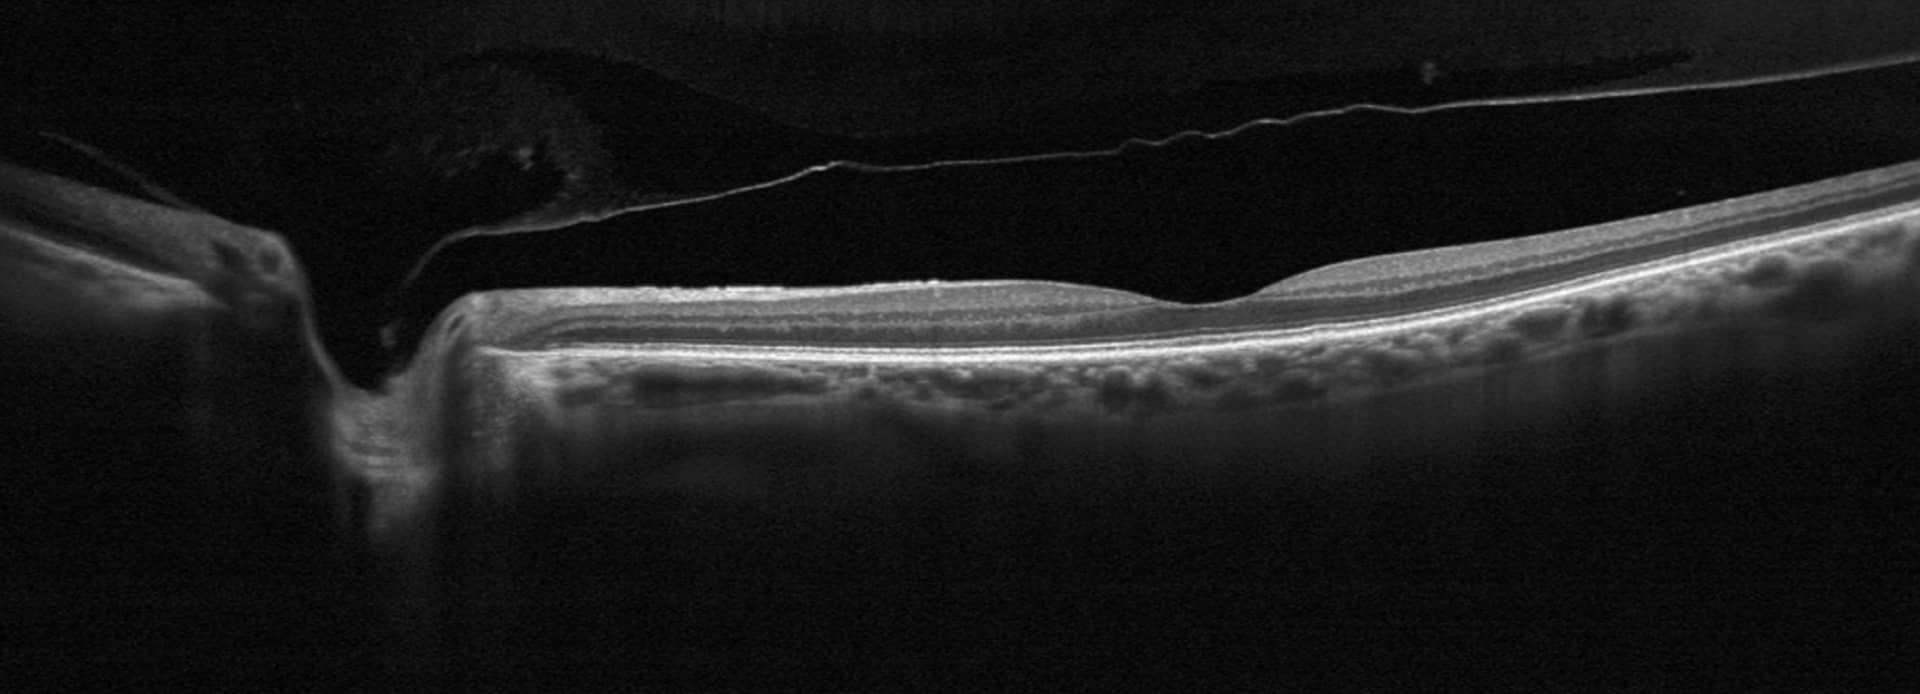
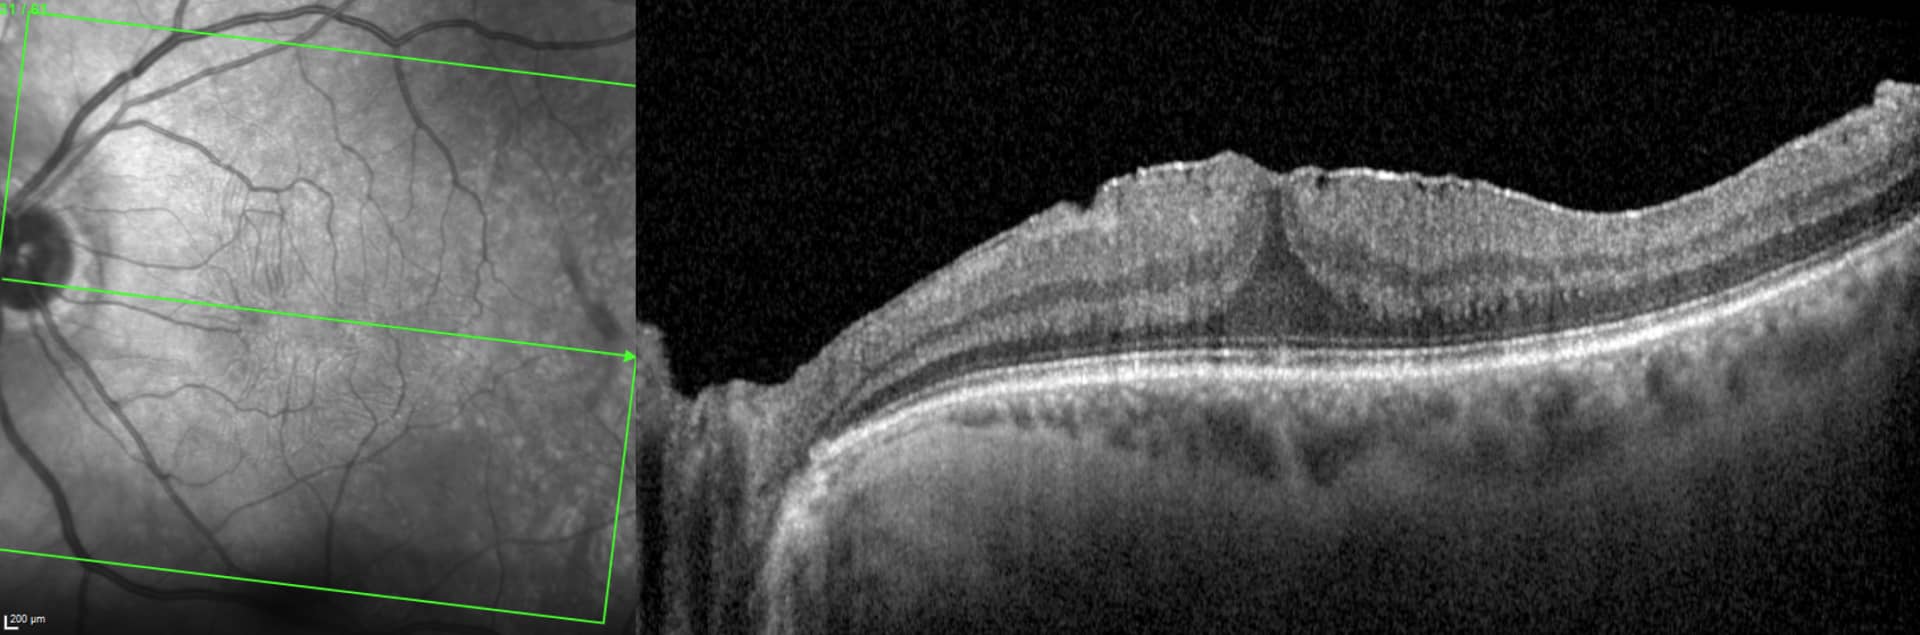

Vitré & rétine
1. Décollement postérieur du vitré
Le décollement postérieur du vitré (DPV) est une affection oculaire courante où le corps vitré, la substance gélatineuse qui remplit la partie arrière de l’œil, se détache de la rétine. Bien que le DPV soit souvent bénin, il peut parfois entraîner des complications graves comme des déchirures rétiniennes ou un décollement de rétine, nécessitant une surveillance attentive.

Symptômes du décollement postérieur du vitré
Quels sont les symptômes habituels du DPV ?
- Apparition soudaine de corps flottants : Points noirs, fils ou toiles d’araignée qui semblent se déplacer dans le champ visuel. Ils sont plus visibles sur des fonds clairs comme un mur blanc ou le ciel.
- Éclairs lumineux (phosphènes) : Perçus souvent en périphérie du champ de vision, ces éclairs sont causés par la traction du vitré sur la rétine.
- Vision floue ou réduite : Parfois, les corps flottants peuvent perturber temporairement la vision. Il peut aussi survenir un saignement dans la cavité vitréenne qui peut brouiller la vision.
Ces symptômes, bien qu’inhérents au DPV, peuvent être similaires à ceux de complications plus graves comme la déchirure rétinienne ou le décollement de rétine. Il est donc crucial de consulter un ophtalmologiste dès l’apparition de ces signes pour écarter ces deux complications.
Traitement du décollement postérieur du vitré
Le DPV est un processus naturel lié au vieillissement. En l’absence de complications, les corps flottants et les éclairs lumineux diminuent souvent avec le temps, bien que certains corps flottants puissent persister.
Quelles sont les options thérapeutiques ?
En fonction du diagnostic réalisé par votre ophtalmologue, il vous détaillera les différentes options thérapeutiques.
En somme, le DPV est bénin, mais l’apparition brutale d’un des signes mentionnés plus haut doit amener à une évaluation rapide pour écarter toute complication rétinienne et éviter des dommages plus graves.
2. Décollement de rétine (rhegmatogène)
Le décollement de rétine est une urgence ophtalmologique caractérisée par la séparation de la rétine neurosensorielle de l’épithélium pigmentaire sous-jacent. Privée de son apport en oxygène et en nutriments, la rétine peut subir des dommages permanents et entraîner une perte de vision irréversible si elle n’est pas traitée rapidement.

Facteurs de risque du décollement de rétine rhegmatogène :
Plusieurs facteurs augmentent le risque de décollement de rétine :
1.Myopie élevée : Les personnes très myopes sont plus à risque en raison de l’étirement de la rétine et de sa plus grande fragilité.
2.Traumatismes oculaires : Les blessures peuvent provoquer des déchirures dans la rétine, entraînant un décollement.
3.Antécédents de chirurgies oculaires : Une chirurgie comme la cataracte augmente le risque de décollement de rétine.
4.Antécédents familiaux : Un décollement de rétine dans la famille peut aussi accroître le risque.
5.Dégénérescences rétiniennes : zone de fragilité de la rétine.
6.Trous rétiniens
7.Antécédents de décollement de la rétine
Quels sont les symptômes du décollement de rétine ?
– Éclairs lumineux (phosphènes) dans le champ de vision, surtout en périphérie.
– Apparition soudaine de corps flottants : petits points ou filaments sombres dans la vision.
– Ombre ou rideau noir dans le champ visuel, qui s’étend progressivement si le décollement s’aggrave.
Les symptômes sont souvent indolores, ce qui peut retarder la consultation.
Quels sont les traitements du décollement de rétine ?
Le traitement dépend de la gravité et du type de décollement. Il vise à réappliquer la rétine contre sa couche sous-jacente et à sceller les déchirures :
1.Photocoagulation au laser : Pour les petites déchirures, un laser peut “souder” la rétine, prévenant l’évolution vers un décollement.
2.Cryothérapie : Cette technique gèle les déchirures rétiniennes pour sceller la rétine.
3.Vitrectomie : Une intervention chirurgicale qui consiste à retirer le corps vitré, souvent remplacé par une solution spéciale pour réappliquer la rétine.
4.Indentation sclérale : Un dispositif est suturé autour de l’œil pour exercer une pression et maintenir la rétine en place.
5.Rétinopexie pneumatique : Une bulle de gaz est injectée dans l’œil pour appuyer la rétine contre sa couche de support. Le patient doit maintenir une position de tête spécifique pour garantir le succès de la procédure.
Le décollement de rétine nécessite une intervention rapide pour éviter la perte de vision. Les personnes à risque ou présentant des symptômes doivent consulter un ophtalmologue sans attendre.
3. Choriorétinite séreuse centrale (CRSC)

CRSC : qu’est-ce que c’est ?
La choriorétinite séreuse centrale (CRSC) est une affection de l’œil qui touche la rétine, la couche sensible à la lumière située au fond de l’œil. Elle se manifeste par une accumulation de liquide sous la rétine, provoquant une déformation temporaire de cette dernière et des troubles visuels. Bien que souvent bénigne et transitoire, la CSC peut nécessiter une prise en charge adaptée.
La CRSC survient lorsque le liquide provenant de la choroïde (couche vasculaire sous la rétine) traverse l’épithélium pigmentaire rétinien, formant une poche de liquide sous la rétine centrale (macula). Cela altère la vision, notamment la perception des formes et des couleurs.
Quels sont les facteurs de risque ?
Plusieurs facteurs peuvent augmenter le risque de CSC :
- Stress : Un stress important ou chronique, favorisant une production excessive de cortisol, hormone qui peut affecter la rétine.
- Corticostéroïdes : L’utilisation de médicaments à base de cortisone (par voie orale, injectable ou topique).
- Autres facteurs (débattus) : Troubles du sommeil, consommation de stimulants (caféine, alcool), hypertension artérielle.
La CRSC touche souvent les hommes jeunes ou d’âge moyen (25-50 ans).
Quels sont les symptômes ?
Les principaux signes de la CRSC incluent :
- Vision floue ou déformée (métamorphopsies).
- Perception d’une tache sombre ou floue au centre du champ visuel (scotome central).
- Sensation que les couleurs sont moins intenses.
- Difficulté à voir de près.
Quels sont les traitements ?
La CRSC est souvent auto-limitée et peut se résoudre spontanément en quelques semaines à mois. Cependant, un suivi médical est essentiel. Les options de traitement incluent :
- Observation : Si les symptômes sont légers et récents.
- Photothérapie : La photothérapie dynamique (PDT) peut être utilisée pour réduire la perméabilité des vaisseaux choroïdiens.
- Laser sous le seuil (subthreshold) : modalité thérapeutique pouvant être utilisée reposant sur le même principe que la PDT.
Prévention et Conseils
- Limitez le stress par des techniques de relaxation ou une meilleure gestion des émotions.
- Évitez l’usage prolongé ou inapproprié de corticoïdes.
- Adoptez un mode de vie sain pour réduire les risques associés (hypertension, insomnie).
Si vous remarquez des troubles visuels persistants, une consultation chez un ophtalmologue est indispensable. La détection précoce de la choriorétinite séreuse centrale permet une meilleure prise en charge et prévient les complications.
4. Trou maculaire

Qu’est-ce que c’est qu’un trou maculaire ?
Le trou maculaire est une dégénérescence rétinienne fovéolaire, uni ou bilatérale, résultant principalement d’une traction vitréo-maculaire importante.
Les facteurs de risque comprennent l’âge > 65 ans et le sexe féminin.
Quels sont les symptômes ?
- Baisse d’acuité visuelle variable
- Métamorphopsies ou micropsies
- Scotome central
La réalisation d’OCT maculaire est l’examen de référence pour diagnostiquer un trou maculaire. Il permet également d’éliminer les diagnostics différentiels.
Quelles options thérapeutiques ?
En cas de formes avancées et symptomatiques, le traitement est principalement chirurgical :
- Vitrectomie
- Pelage de la membrane limitante interne
- Pelage d’une éventuelle membrane épirétinienne
- Tamponnement interne par gaz
- Positionnement post-opératoire
Votre ophtalmologue pourra volontiers vous donner de plus amples informations à ce sujet
5. Membrane épirétinienne
Qu’est-ce que c’est qu’une membrane épirétinienne ?
Les membranes épirétiniennes maculaires sont des proliférations gliales avasculaires à la surface de la rétine souvent limitées au pôle postérieur.
Il existe des membranes épirétiniennes idiopathiques, à la suite d’un DPV , ou secondaires (après rétinopathies vasculaires, inflammation intra-oculaire, hémorragie intravitréenne, déchirure rétinienne, chirurgie intra-oculaire…).
Les symptômes comprennent :
– Une baisse d’acuité visuelle
– Des métamorphopsies (lignes déformées)
– Micropsie/macropsie (anomalie de la taille des lettres)
– Diplopie monoculaire (vision double de l’œil atteint)
Quels sont les traitements ?
En cas de formes avancées symptomatiques, le traitement est principalement chirurgical en réalisant :
– Une vitrectomie centrale
– Un pelage de la membrane en question et de la membrane limitante interne .
concomitamment
D’autres informations vous seront données par votre ophtalmologue si la situation se présente.
6. Occlusions veineuses rétiniennes (OVR)

Occlusions veineuses rétiniennes : de quoi parle-t-on ?
Il s’agit d’une obstruction et/ou un ralentissement du flux veineux soit au niveau du nerf optique (occlusion de la veine centrale de la rétine), soit au niveau d’un croisement artérioveineux (occlusion de branche veineuse rétinienne). Ces deux types d’occlusion diffèrent par le mécanisme physiopathologique. En effet, l’occlusion veineuse centrale de la rétine (OVCR) est dû, supposément, à un ralentissement circulation induisant une thrombose au niveau du tronc veineuse situé au centre du nerf optique. L’occlusion de branche veineuse est causée par un endurcissement d’une artériole au niveau d’un croisement avec une petite veine causant sa compression.
Quels sont les symptômes ?
– Baisse d’acuité visuelle unilatérale plus ou moins profonde
– Pas de douleur ni rougeur
Quels sont les facteurs de risques ? (Odds Ratio)
– Age (1,04)
– Diabète (0,6 à 1,4)
– Hypertension artérielle (2,2 à 4,2)
– Glaucome / hypertonie oculaire (2,1 à 5,3)
– Tabac (1,88)
– Surpoids (2,16 à 3,88)
– Apnée du sommeil (1,94)
– Hyperlipidémie (1,2 à 2,1)
(Certains de ces facteurs de risque sont sujets à débat dans la littérature scientifique.)
Toute baisse d’acuité visuelle brutale unilatérale doit être investiguée rapidement par un ophtalmologue.
Le traitement est variable en fonction de la présentation clinique et oscille entre injections intravitréennes d’anti-VEGF, laser, équilibre des facteurs favorisants et traitement d’un éventuel glaucome
7. Occlusions artérielles rétiniennes (OAR)

Occlusions artérielles rétiniennes : de quoi parle-t-on ?
Il s’agit d’une thrombose du système artériel de la rétine neurosensorielle pouvant survenir à différentes localisations (Artère centrale [57%], branche de l’artère centrale [38%], artère cillio-rétinienne [5%])
Quels sont les symptômes ?
– Baisse d’acuité visuelle brutale unilatérale plus ou moins profonde
– Amputation brutale d’une partie du champ visuel
– Pas de douleur ni rougeur oculaire
Quels sont les causes et facteurs de risques ?
– Emboles athéromateux (HTA, diabète, dyslipidémie, athérome carotidien)
– Emboles cardiaques (valvulopathie cardiaque, trouble du rythme, dissection carotidienne)
– Maladie de Horton, vascularites et collagénoses systémiques
– Traumatisme oculaire important
– Plus rarement : drusens papillaires, foyer toxoplasmique, boucle artérielle pré-papillaire, trouble
de la coagulation, endocardite
Une occlusion artérielle rétinienne est une urgence médicale ! C’est un AVC avant preuve du contraire et ceci doit être exclu en priorité de l’atteinte sur l’œil. En effet, c’est parfois le seul signe d’une maladie systémique potentiellement létale.
Un bilan systémique et cardiovasculaire doit en ce sens être réalisé en urgence pendant une courte hospitalisation !
Une angiographie rétinienne est également souvent réalisée par votre ophtalmologue, afin de vérifier l’état de perfusion rétinienne au décours.
Le traitement est organisé conjointement avec les équipes de neurologie, cardiologie et radiologie interventionnelle dans le cas d’une indication éventuelle à une thrombolyse systémique.
Un suivi ophtalmologique et systémique au long cours est ensuite requis.
Toute baisse d’acuité visuelle brutale unilatérale doit être investiguée rapidement, si possible dans les 6h suivant le début des symptômes, par un ophtalmologue.
Dans cette pathologie chaque minute compte !

